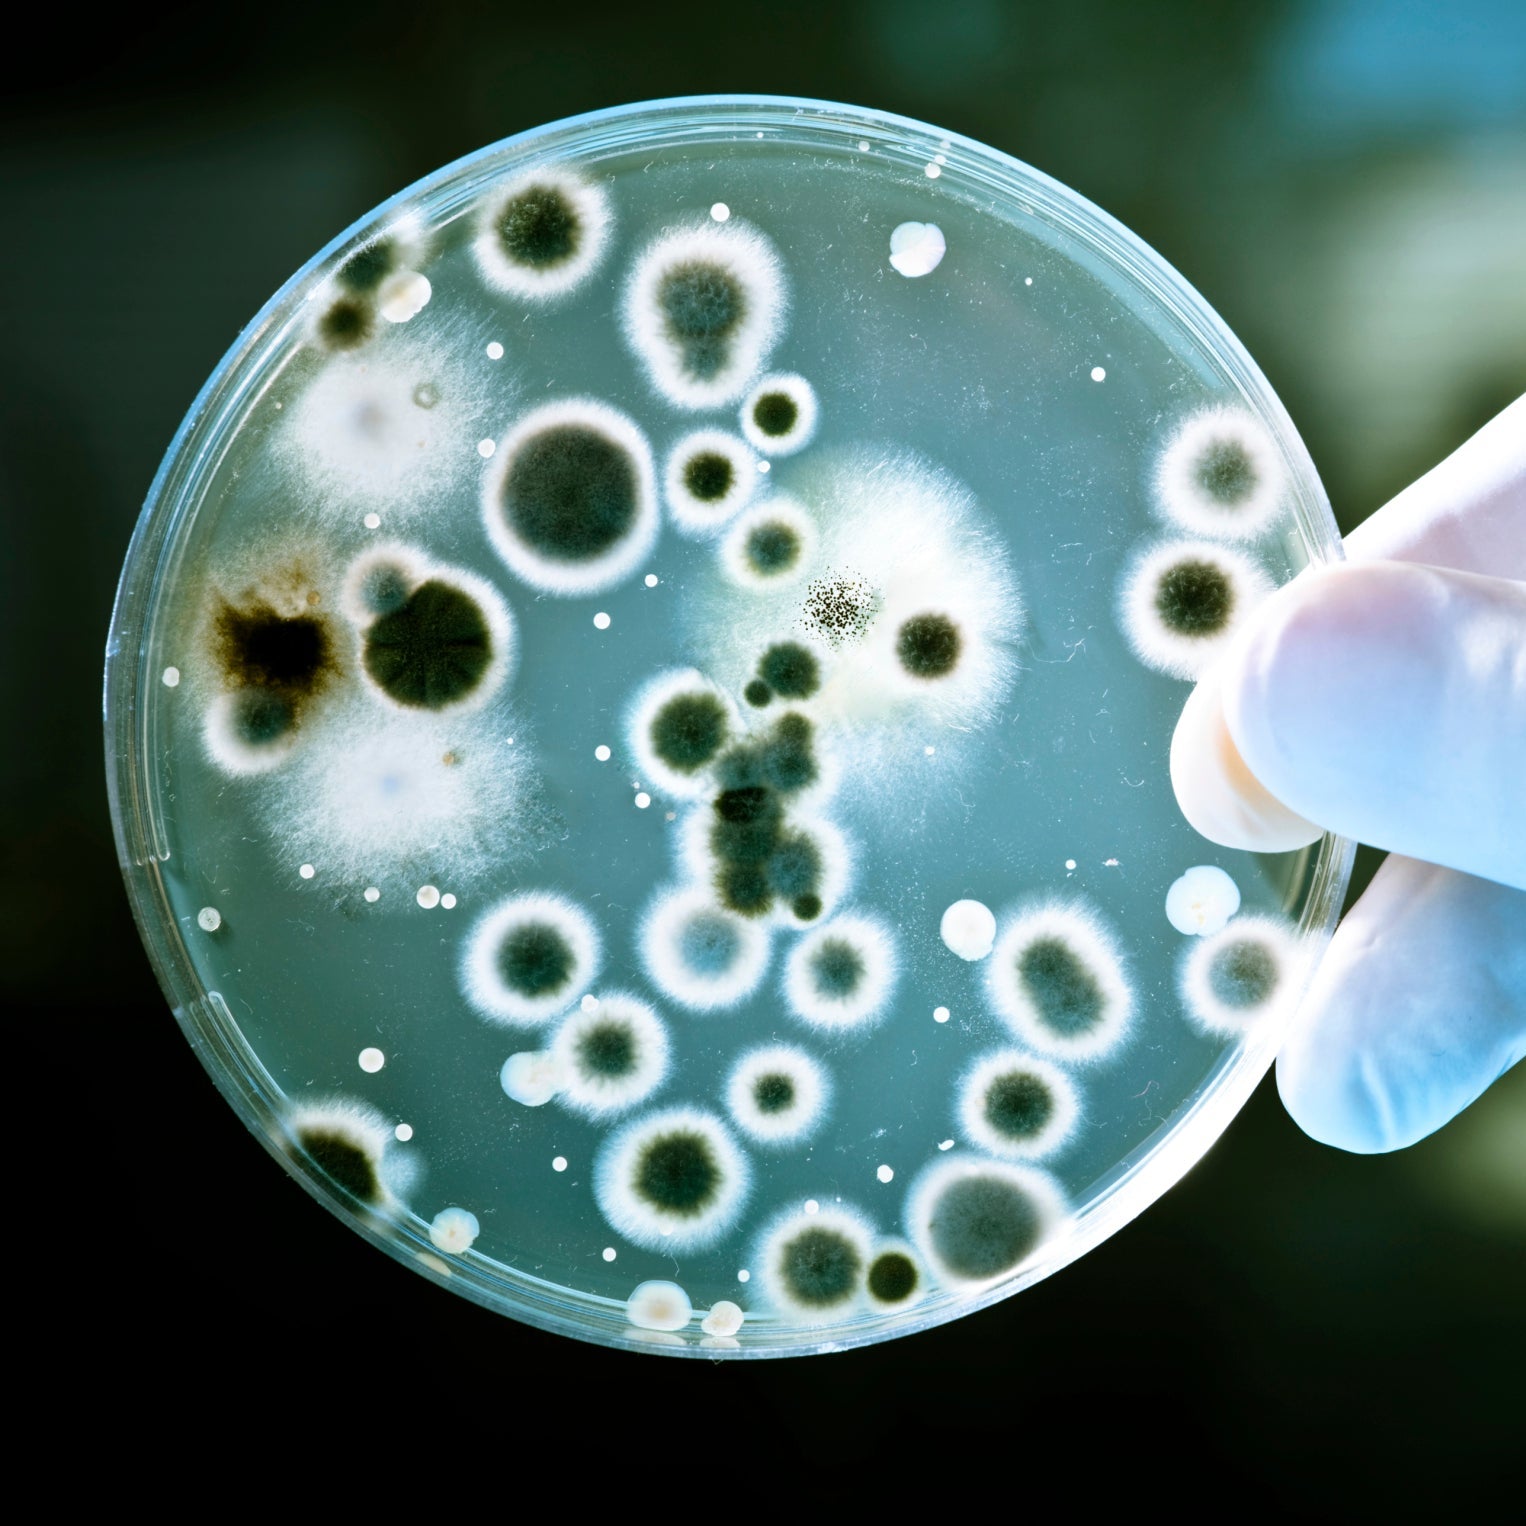
BACTERIA
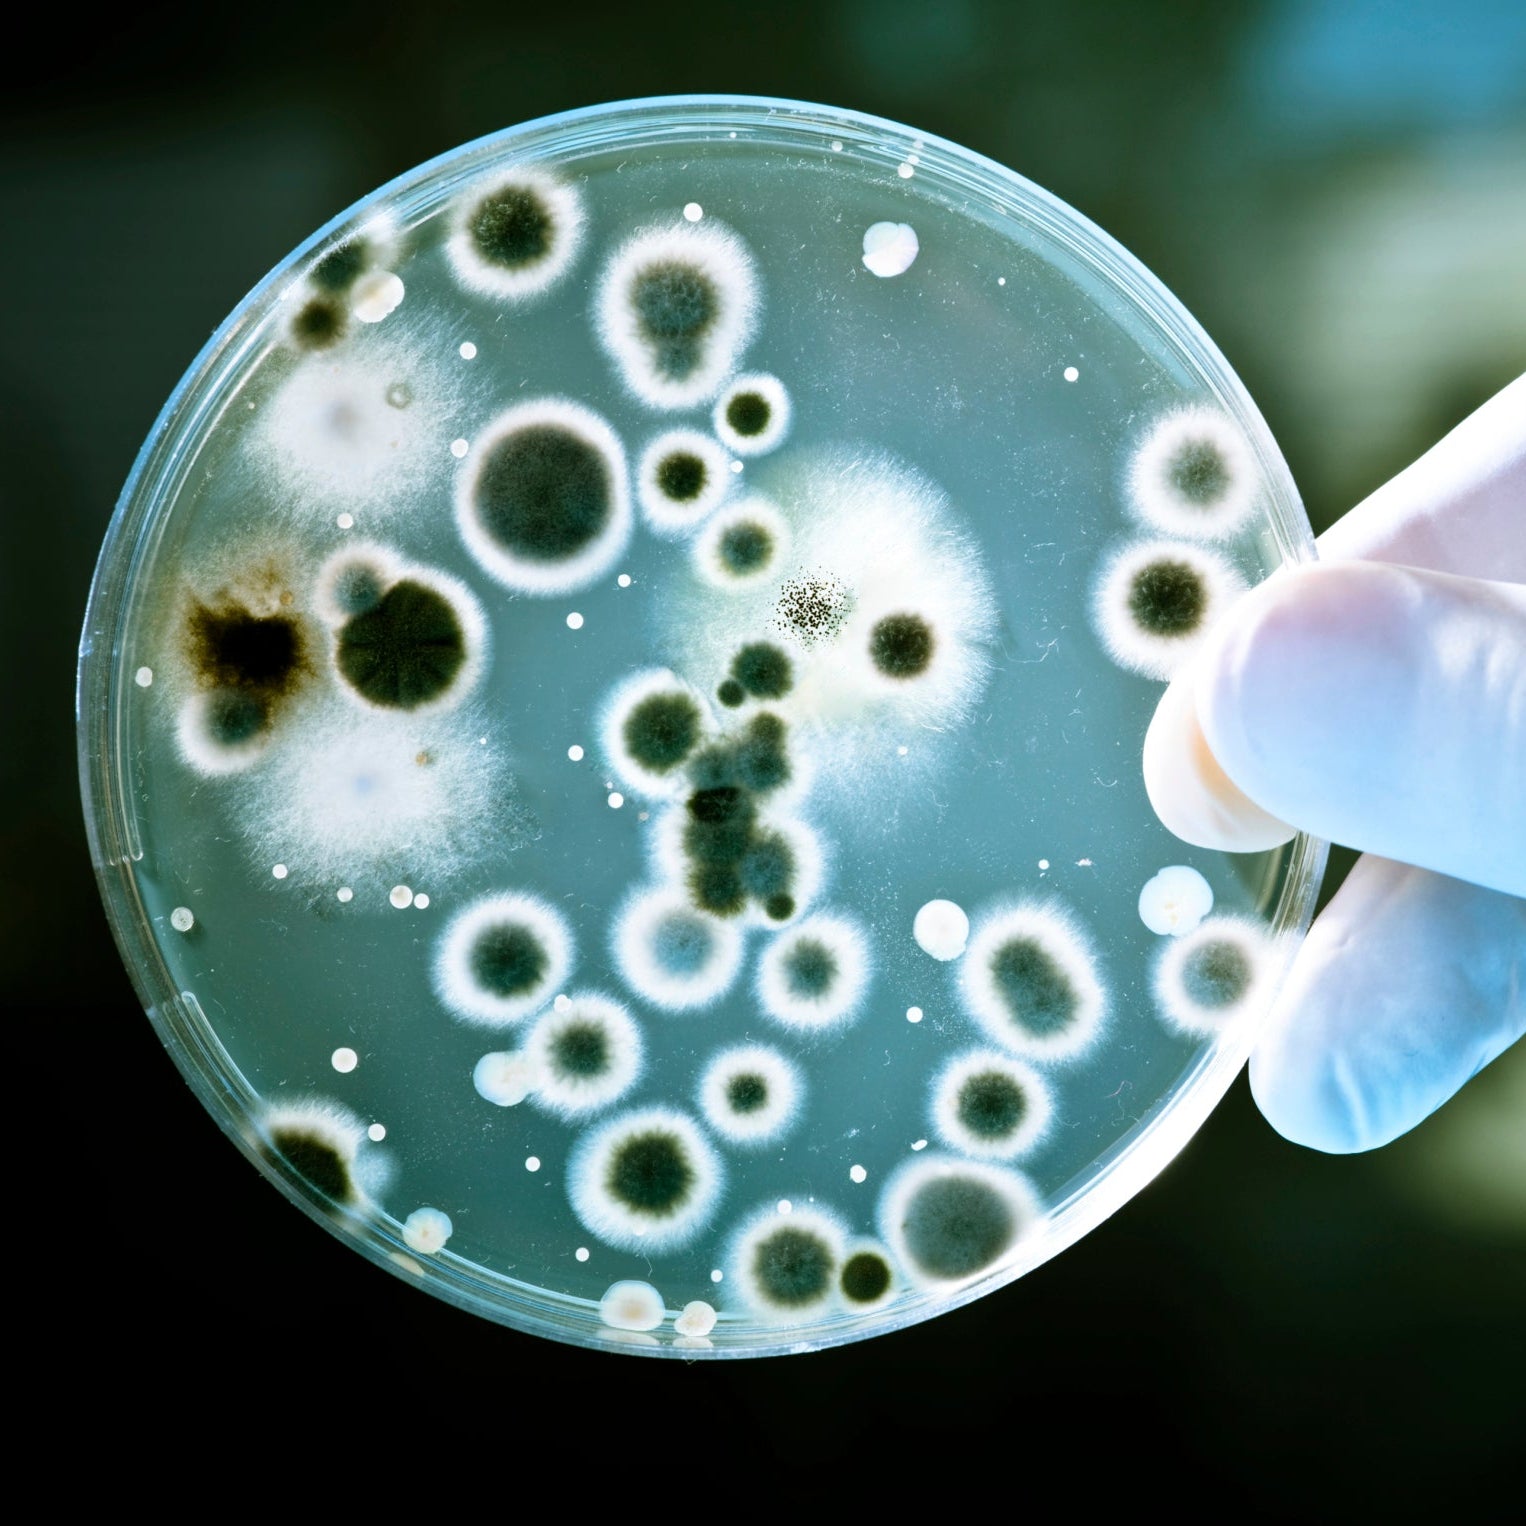
BACTERIA

Australia's #1 Tap & Shower filter brand, install in under 2 minutes fitting 98% of taps.


Tap water has so many contaminants due to aging infrastructure, agricultural runoff, industrial pollution, and chemical disinfection processes

Watau filters provide 1,200 liters of clean water for less than $0.01 P/L, compared to $1 for bottled water P/L. Reducing plastic waste, benefiting your wallet and the planet

It goes without saying these impurities negatively affect our bodies daily when consumed. From serious health issues to smelly and bad tasting water, our filter helps removes it

Installation of our filter is quick and simple only taking only a few minutes without requiring a professional. Our recurring plans make sure you never go without a clean and functional filter.


As the filter works to reduce impurities, it gradually becomes saturated. For optimal performance, we recommend replacing the cartridge every 2–3 months.